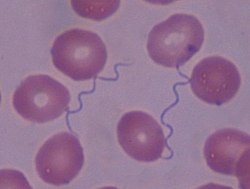

Spirochaete
 From Rationalwiki
From Rationalwiki A Spirochaete is any member of the phylum Spirochaetes (literally "Spiral hairs"), a group of distinctive, Gram-negative bacteria, which possess long, helically coiled cells. Spirochetes are chemoheterotrophic, and reach lengths between 5 and 250 µm and diameters around 0.1-0.6 µm.
Spirochetes are also different from many bacterial phyla in the way that they have flagella that lie between the cell membrane and outer membrane, running lengthwise. These special flagella are termed axial filaments, and their movement causes the spirochaete to twist, thus allowing it to move forward or backward, much in the same manner a screw moves forward or backward when turned.
One of the most important spirochaete genera (in relation to humans, at least) is the genus Treponema, which contains two important disease-causing species, Treponema pallida, the pathogen of syphilis, and Treponema pertenue, the pathogen of yaws.[1]
References[edit]
Categories: [EvoWiki ports] [Evolution] [Microbiology]
↧ Download as ZWI file | Last modified: 11/05/2025 10:37:15 | 8 views
☰ Source: https://rationalwiki.org/wiki/Spirochaete | License: CC BY-SA 3.0
KSF
KSF